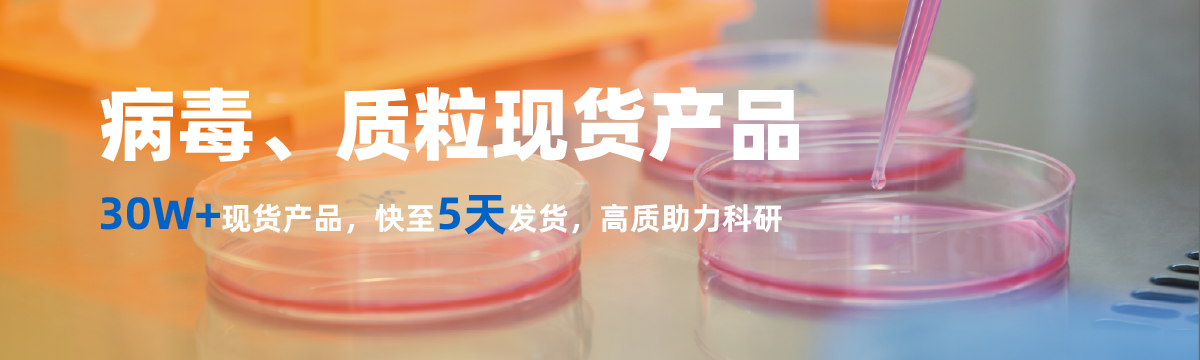
banner

上海吉凯基因医学科技股份有限公司
上海吉凯基因医学科技股份有限公司品牌商
15 年
手机商铺
商家活跃:
产品热度:
- NaN
- 0.5
- 0.5
- 1.5
- 0.5
精品推荐0
- 现货产品
- 基因调控
- 细胞动物分子检测实验整包服务
- 质谱
- NGS
该分类产品即将上线哦~
商铺视频查看全部
热门推荐查看全部
关于我们查看全部

上海吉凯基因医学科技股份有限公司
吉凯基因成立于2002年,致力于为客户提供从基础研究到新药发现与开发全流程的技术服务及解决方案。业务覆盖基因研究、靶标发现、靶点验证、新药开发、新药评价等阶段,致力转化医学,赋能新药创制。吉凯基因是上海肿瘤药物基因靶标工程技术研究中心,与全国300多家三甲医院,数万名临床医生建立合作关系,在上海市科创办重大项目的支持下,开发了以医疗大数据为基础的靶标发现体系。同时,吉凯基因是上海首批技术创新中心——基因治疗技术创新中心,持续致力于帮助客户开发CGT产品。 截至2022年12月,吉凯基因已为全球300余家合作单位完成项目超10万项,承担国家/地方研发项目40余项。吉凯基因病毒工具平台为行业输出Lenti、AdV、AAV、HSV等病毒载体, 年处理病毒订单